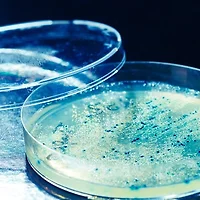

기온이 영하로 떨어지면 야외에서 운동하는 것이 아무래도 망설여진다. 날씨가 춥고, 기온이 온화한 계절보다 조심해야 할 것들이 늘어나니 여러모로 번거롭다. 하지만 겨울철 야외 달리기를 즐기는 사람들은 한여름보다 겨울이 오히려 달리기에 더 좋다고 말한다. 여름에는 높은 습도와 열기 탓에 오래 달리지 않아도 금세 지치지만 겨울에는 옷만 잘 갖춰 입으면 장시간 달리는 일이 여름보다 수월하다. 겨울에는 야외 운동에 나서는 사람이 여름보다 적어 호젓한 분위기를 만끽할 수 있다는 것도 장점이다.
최근 미국 일간 워싱턴포스트는 겨울철 달리기가 두렵거나 어려운 사람들을 위해 전문가들의 도움말을 소개했다. 이 기사에서 전문가들은 겨울 달리기가 어려운 이유에 대해 “추운 날씨가 아니라 잘못 입은 옷이 문제”라고 지적했다. ‘서툰 목수가 연장 탓 한다’는 말도 있지만 체온 관리가 필수적인 겨울 달리기에서 연장, 즉 옷차림은 중요하다. 옷차림을 포함해 겨울철 야외 달리기 때 알아두면 좋을 요령을 정리했다.
날씨가 추울 때 옷을 얇게 입으면 손발과 얼굴이 얼지만 너무 두껍게 입어도 활동성이 떨어져 뛰기에 좋지 않다. 워싱턴DC에서 육상 코치로 일하는 캐시 퓨는 워싱턴포스트와의 인터뷰에서 “각자 자신에게 알맞은 옷차림을 찾아내야겠지만 일반적으로는 실제 기온보다 6도가량 높다고 가정한 뒤 여기에 맞춰 옷을 입는 게 좋다”고 권했다. 현재 바깥 기온이 영하 7도라면 영하 1도일 때 입을 법한 옷차림을 해야 한다는 것이다. 일단 뛰기 시작하면 체온이 오를 테니 이를 감안해 옷을 입으라는 얘기다.
이와 함께 바깥 공기와 직접 맞닿는 피부 면적을 최소화해야 한다는 점도 유념해야 한다. 눈만 내놓고 머리와 얼굴, 목을 덮는 마스크(발라클라바)를 착용하면 피부를 차가운 공기로부터 보호할 수 있다. 워싱턴포스트는 “일기 예보를 확인할 때 기온뿐만 아니라 풍속을 알아보라”고 조언했다. 바람이 세게 불면 체감 기온이 더 떨어지므로 옷을 어떻게 입을지 결정할 때 풍속도 고려해야 한다는 것이다.
겨울철 야외 달리기의 가장 큰 난관은 사실 낮은 기온이 아니라 미끄러운 길이다. 눈이 얼거나 결빙이 일어난 길을 달리는 것은 자칫 사고를 부를 수 있어 위험하다. 도로 사정이 나쁘지만 운동을 하고 싶을 때는 두 가지 대안이 있다. 첫 번째 대안은 야외 달리기와 비슷한 강도로 실내 운동을 하는 것이다. 예를 들어 야외에서 1시간 동안 약간 빠른 속도로 뛸 계획이었다면 실내에서 역시 1시간 동안 숨이 찰 정도의 속도와 강도로 자전거를 타는 것이다.
도로 사정이 좋지 않을 때도 야외 운동을 하고 싶다면 달리기 코스의 특성을 잘 파악해두는 것이 필요하다. 쌓인 눈이 녹지 않고 몇날며칠 얼어있는 곳도 있지만 눈이 쌓이지 않아 달리기에 괜찮은 곳도 있을 것이다. 이렇게 길이 미끄럽지 않은 곳을 찾아내 이 구간을 반복해서 달리는 게 요령이다.
겨울철 야외 달리기를 하려면 날씨가 온화할 때보다 몸 풀기(워밍업)를 더 많이 해야 한다. 스트레칭을 한번 하더라도 동작을 더 크고 빠르게 해서 체온이 상승하도록 한다. 겨울철엔 체온을 일정하게 유지하기 위해 더 많은 에너지가 필요하다. 식사를 든든하게 하고, 갈증이 느껴지지 않더라도 1시간에 적어도 120㎖ 이상 수분을 섭취해야 한다.
페이스 조절도 중요하다.처음 1㎞ 정도는 편안하고 여유 있게 달리다가 몸이 풀린 후에 속도를 올리는 게 좋다. 달리기가 끝난 후에는 체온이 떨어지지 않도록 신경 써야 한다. 마무리 스트레칭은 집으로 돌아와 실내에서 하고, 스트레칭이 끝난 후엔 곧장 따뜻한 물로 샤워하도록 한다.
겨울은 해가 짧기 때문에 아침 출근 전이나 저녁 퇴근 후에 운동하러 밖에 나가면 어둠 속에서 달려야 하는 상황이 벌어진다. 이럴 때 친구 또는 동호회 사람들과 함께 달리면 행여 어두운 곳에서 미끄러져 넘어지더라도 주변의 도움을 받을 수 있어 혼자 달릴 때보다 훨씬 안전하게 운동을 즐길 수 있다. 달리기 복장을 고를 때도 자전거 또는 자동차 운전자들이 내 위치를 식별할 수 있도록 밝은 색상이나 반사되는 옷을 입는 게 좋다.
글 / 최희진 경향신문 기자
'건강 > 생활' 카테고리의 다른 글
| A형 지나니 B형, 빨리 찾아온 봄철 독감 (3) | 2017.02.06 |
|---|---|
| 내 몸 안에 칼바람이 분다, 참을 수 없는 ‘통풍’ (1) | 2017.01.31 |
| 하늘위에서 발생한 응급상황, 기내응급상황 대처법 (1) | 2017.01.02 |
| 연말연시 다짐 1위, 담배는 의지로 끊어야 (1) | 2016.12.30 |
| 당신의 손에 묻어있는 것, 감염병 예방 수칙 (1) | 2016.12.21 |